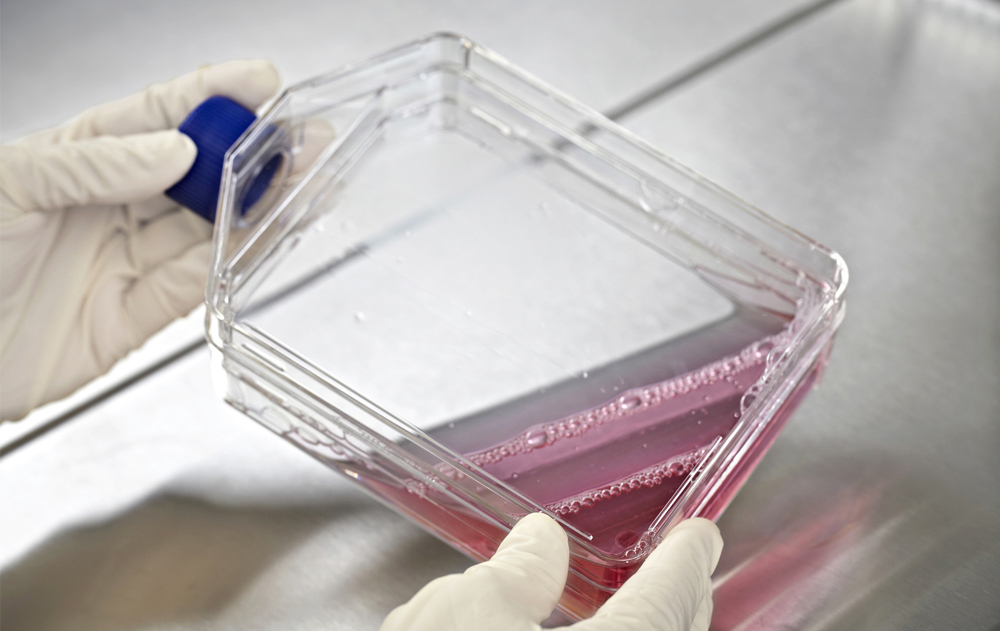

Sotio
SOTIO, part of PPF Group, is a biotechnology company that is developing next-generation Active Cellular Immunotherapy, focusing on the treatment of cancer and autoimmune diseases.
Quantarex worked with SOTIO to bring their technology to the United States. While they were in their labs running clinical trials, we were in the background establishing their legal presence; ensuring they met US regulatory standards and running their back office processes so they can focus on their goal.
Today, they are continuing their development in the United States while growing their team in Boston, Massachusetts.